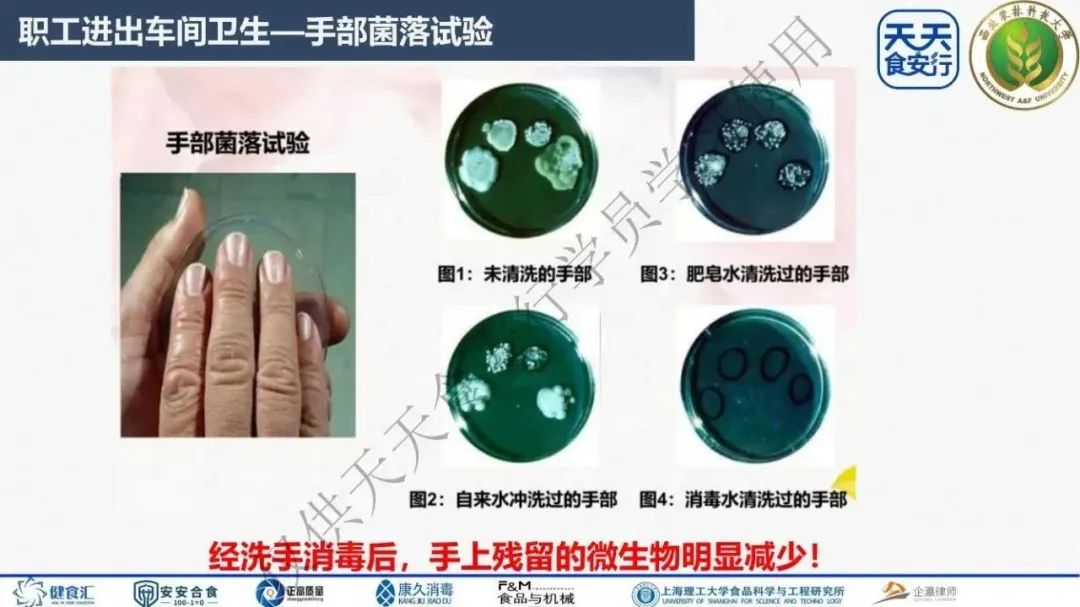

文章编辑:天天食安行
内容来源:原创




















































今日直播预告
2023年03月28日下午14:00-15:00,天天食安行·公益大讲堂邀请到:海乐香辛料(济南)有限公司质量经理,ISO9001,ISO22000,HACCP审核员马力老师,给大家分享《识别、消除--企业七大浪费》。点击下图长按“识别图中的二维码”,提前登记、预约直播课程。公益讲座,不收取任何费用

文章编辑:天天食安行
内容来源:原创

今日直播预告
2023年03月28日下午14:00-15:00,天天食安行·公益大讲堂邀请到:海乐香辛料(济南)有限公司质量经理,ISO9001,ISO22000,HACCP审核员马力老师,给大家分享《识别、消除--企业七大浪费》。点击下图长按“识别图中的二维码”,提前登记、预约直播课程。公益讲座,不收取任何费用
